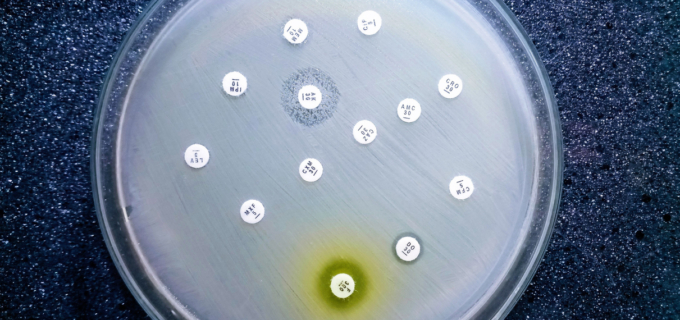
L’OMS alerte sur une résistance mondiale croissante aux antibiotiques

- Accueil ›
- Conseils ›
- Maux du quotidien ›
- Pollution de l’air : un terrain d’action pour les pharmaciens

© Getty Images
Pollution de l’air : un terrain d’action pour les pharmaciens
À l’occasion de la Journée nationale de la qualité de l’air, ce mardi 14 octobre, Santé publique France et l’Académie nationale de pharmacie publient de nouvelles données. Si la qualité de l’air s’améliore, les expositions restent préoccupantes, notamment en milieu intérieur, et appellent à une mobilisation accrue de toutes les acteurs.
Publiés les 13 et 14 octobre 2025, le communiqué de Santé publique France et l’avis de l’Académie nationale de pharmacie dressent un même constat : la pollution de l’air, extérieure comme intérieure, demeure un enjeu majeur de santé publique. Selon Santé publique France, environ 40 000 décès annuels seraient attribuables à l’exposition chronique aux particules fines (PM₂,₅, inférieures à 2,5 µm) chez les adultes de plus de 30 ans, avec un impact économique estimé à 130 milliards d’euros.
Une amélioration mesurable mais encore insuffisante
Les données récentes confirment une baisse globale des concentrations de polluants atmosphériques en France, hormis pour l’ozone. La nouvelle directive européenne sur la qualité de l’air adoptée en 2024 fixe toutefois des seuils plus stricts à atteindre d’ici 2030.
Santé publique France souligne que près de 30 000 cas d’asthme pédiatrique pourraient être évités chaque année si les niveaux de particules fines respectaient les recommandations de l’Organisation mondiale de la santé. L’agence rappelle également que l’air intérieur, souvent plus pollué que l’air extérieur, expose à de multiples contaminants : particules, oxydes d’azote, composés organiques volatils ou agents biologiques (acariens, moisissures).
L’Académie de pharmacie mobilise les professionnels de santé
Dans son avis du 1ᵉʳ octobre 2025, l’Académie nationale de pharmacie s’appuie sur les résultats de la campagne nationale Logement 2 (2020-2023) menée par l’Observatoire de la qualité des environnements intérieurs. Elle confirme une diminution de nombreux polluants (COV chlorés, aldéhydes, PM₂,₅), mais relève encore des dépassements pour le formaldéhyde, le dioxyde d’azote, le radon et le benzène.
L’Académie recommande d’actualiser le cadre réglementaire de la ventilation, de renforcer la formation des conseillers en environnement intérieur et d’impliquer davantage les pharmaciens dans la prévention des expositions domestiques. Ces derniers sont identifiés comme relais essentiels d’information et de dépistage lors des entretiens pharmaceutiques ou du dispositif « Mon bilan prévention ».
- Comptoir officinal : optimiser l’espace sans sacrifier la relation patient
- Reishi, shiitaké, maitaké : la poussée des champignons médicinaux
- Budget de la sécu 2026 : quelles mesures concernent les pharmaciens ?
- Cancers féminins : des voies de traitements prometteuses
- Vitamine A Blache 15 000 UI/g : un remplaçant pour Vitamine A Dulcis